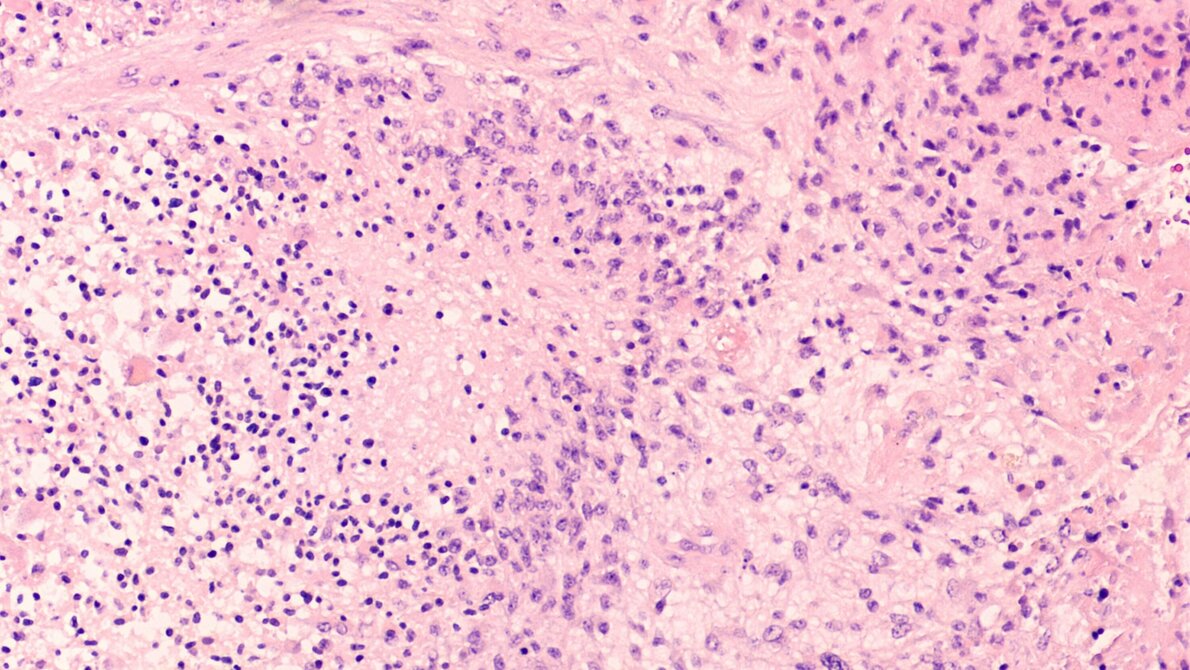
Glioblastom

Die Substanz Cannabidiol (CBD) ist ein weit verbreitetes Nahrungsergänzungsmittel und Lifestyle-Produkt – beispielsweise zur Therapie von entzündungsbedingten Erkrankungen. CBD wird teilweise auch eingenommen, um die Stimmung zu heben oder Schlaflosigkeit zu bekämpfen. Das aber ist keineswegs unumstritten, denn die Wirksamkeit dieser Lifestyle-Präparate ist nach wissenschaftlichen Standards nicht belegt. Nun haben Forscher/-innen des LMU Klinikums nach eigenen Angaben „eindeutige Beweise für den tumorbekämpfenden Effekt“ von hochreinem CBD bei grundlagenwissenschaftlichen Modellen für bösartige Hirntumor-Zellen (Glioblastome) nachgewiesen, wie Studienleiter Prof. Dr. Rainer Glaß von der Neurochirurgischen Klinik und Poliklinik am LMU Klinikum München in Großhadern betont. Sein Team hat sogar den Wirkmechanismus aufgeklärt.
Nur ein einziges Produkt von der EMA zugelassen
Unter den vielen CBD-Produkten, die auf dem Markt kursieren, ist nach Angaben des Biologen keines zu empfehlen. „Man weiß nie, was man da bekommt, wenn man an Reinheit, Zusammensetzung und Konzentration des Wirkstoffes denkt“, sagt er. Überdies ist nur ein einziges Produkt namens Epidiolex von der Europäischen Arzneimittelagentur für eine medizinische Anwendung zugelassen – und zwar rezeptpflichtig für die Therapie schwerer kindlicher Epilepsien. Alle weit verbreiteten Meldungen über die „allgemein entzündungshemmenden und tumorunterdrückenden Wirkungen von CBD aus Nahrungsergänzungsmitteln sind sehr zweifelhaft“, betont Glaß weiter.
Körpereigene Cannabinoide zur Selbstverteidigung
Allerdings sind seit vielen Jahren in der Wissenschaft Studien bekannt, wonach bestimmte Zellen des Gehirns körpereigene Cannabinoide ausschütten - die auch zur Selbstverteidigung gegen Glioblastome dienen. Das Glioblastom ist der häufigste und zugleich bösartigste Hirntumor, an dem allein in Deutschland jährlich etwa 4.000 Menschen erkranken. Etwa die Hälfte der Patienten überlebt vom Zeitpunkt der Diagnose gerechnet durchschnittlich nur 16 Monate. Neue Behandlungsformen sind deshalb dringend nötig.
Vom Tiermodell zur klinischen Studie
In diesem Wissen und motiviert von den vorangegangenen Studien, haben die Forscher/-innen nun den Effekt von CBD gegen Tumorzellen aus Mäusen und Menschen getestet. Die Zellen wiesen etliche Mutationen auf, die für Glioblastome typisch sind. Resultat: Binnen zwei bis drei Tagen nach Gabe des Cannabidiols sterben diese Glioblastomzellen ab. „CBD induziert den Zelltod bestimmter Glioblastome, es gibt aber auch Tumore, die nicht therapeutisch auf CBD ansprechen“, sagt Glaß. Außerdem haben die Forscher/-innen ermittelt, „dass CBD einen Signalweg blockiert, der ansonsten Entzündungsreaktionen kontrolliert.“ Die Tumorzellen nutzen diesen Signalweg, um immer weiter zu wachsen. Glaß‘ Team hat zudem einen „Marker“ gefunden, der anzeigt, welche Glioblastome höchstwahrscheinlich auf CBD ansprechen werden und welche nicht.
Prämissen für klinische Erprobung seien gut
Gerade die letztgenannte Erkenntnis ist beste Voraussetzung für eine Studie mit Patienten/innen. Die Prämissen für eine klinische Erprobung seien ohnehin gut. Denn zum einen sei Epidiolex von den Zulassungsbehörden hinsichtlich seiner Arzneimittelsicherheit bereits abgesegnet. Zum zweiten dringe die Substanz gut ins Gehirn ein, was nur wenige Wirkstoffe überhaupt schaffen. Und zum dritten sei die Substanz in der Regel so gut verträglich, dass man sie sogar kleinen Kindern verabreichen könne, bestätigt Glaß.
Nur von einem rät Experte Glaß dringend ab: Jetzt CBD-Allerweltspräparate zu schlucken, um sich auf eigene Faust gegen Tumore zu schützen. „Da sollte man besser abwarten, bis die Wissenschaft gute Daten und pharmakologisch einwandfreie Wirkstoffe vorlegen kann - vielleicht sogar nicht nur im Kampf gegen den Krebs, sondern auch zur Therapie anderer Erkrankungen, die auf Entzündungsreaktionen beruhen wie Rheuma oder Neurodermitis und andere.“
Literatur:
Volmar MNM, Cheng J, Alenezi H, et al.: Cannabidiol converts NFκB into a tumor suppressor in glioblastoma with defined antioxidative properties. Neuro Oncol. 2021 Apr 17:noab095, DOI: doi: 10.1093/neuonc/noab095.
Quelle: idw/LMU
Artikel teilen